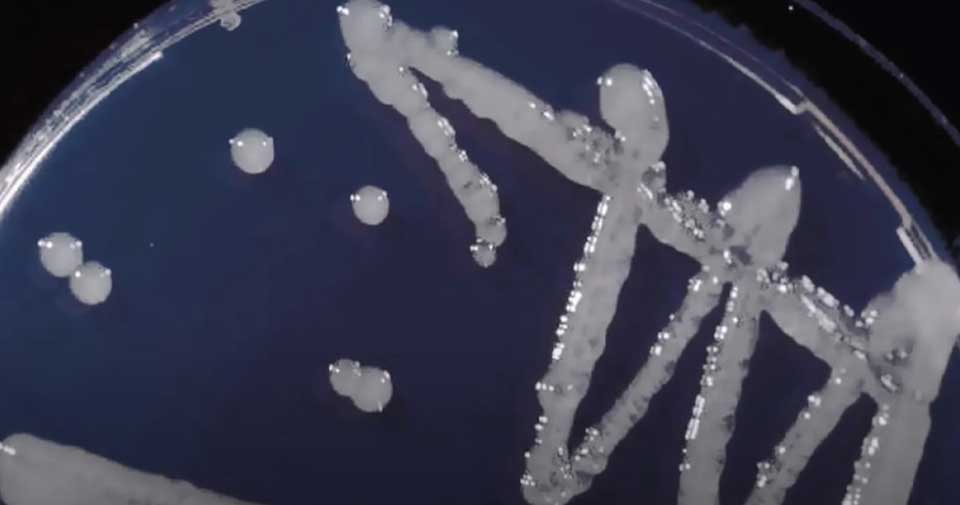

Возбудитель заболевания
Вспышки бактериального ожога плодовых культур на территории России до 2009 не фиксировались. Завозной фитопатоген Erwinia amylovora ранее встречался только на территории Америки, Австралии, Канады. Эрвиния представляет собой палочку, которая может перемещаться в окружающей среде при помощи жгутиков. В перечисленных странах вспышки бактериального ожога груши наблюдались с конца XVIII века.
Продажа заражённого генетического материала помогла бактерии распространиться во все уголки света. И вот эрвиния уже гордо шествует по нашей стране, уничтожая промышленные и любительские сады. Пока столь масштабного распространения недуг не получил. Всероссийский центр карантина растений признал его ограниченно распространённым.
Условия развития болезни
Оптимальные условия для развития болезни складываются при температуре воздуха выше +18°С и относительной влажности 70%. С наступлением благоприятных условий заболевание быстро распространяется. В течение вегетационного периода бактериоз может вызвать сплошное поражение растений, особенно в питомнике.
____________________
На заметку!
Почернение верхушек побегов может быть связано также с выращиванием саженцев на почвах, содержащих избыток извести, что блокирует поступление в растения микроэлементов (бора, магния, марганца).
____________________Фото: Бактериоз рябины
Острый диффузный отит
Провоцирующие факторы: избыточный туалет ушей, попадание воды в ухо, микротравмы кожи НСП, факторы снижения иммунитета (переохлаждение, избыточный загар, ОРВИ, хронические заболевания). Возбудители заболевания: золотистый стафилококк, синегнойная палочка.
Симптомы
Это сильная боль в ухе, заложенность уха, жидкие выделения из слухового прохода в небольшом количестве, также отмечается увеличение заушных или околоушных лимфоузлов, воспаление кожи ушной раковины, может быть повышение температуры, симптомы интоксикации. При осмотре отмечается гиперемия и отёк кожи НСП, кожа неровная, с наложениями прозрачного жёлтого или гноевидного отделяемого, виден слущенный эпидермис. Просвет НСП часто резко сужен и может не определяться барабанная перепонка. Если она видна, то обычно тоже неровная и умеренно гиперемирована. Нередко определяется увеличение и болезненность регионарных лимфоузлов, утолщение, болезненность и гиперемия ушной раковины. Слух при сохранении просвета НСП снижен незначительно или нормальный.
Диагностика
Для постановки диагноза, кроме осмотра, нужно исключить заболевание среднего уха, для чего проводят камертональные пробы (исследование слуха набором камертонов), тимпано- и импедансометрия (измерение подвижности барабанной перепонки), исследование порогов слуха (аудиомерия). Эти исследования проводятся для исключения заболеваний среднего уха. Лабораторная диагностика включает в себя общий анализ крови, сахар крови, посев из больного уха на микрофлору для назначения антибактериальной терапии.
Лечение
Основное направление лечения – это антимикробная и противовоспалительная терапия. Назначаются местно или системно антибиотики, противовоспалительные препараты (нестероидные противовоспалительные препараты, кортикостероиды). При сильной боли хороший эффект от заушных блокад с кортикостероидами и местными анестетиками. Проводится щадящий туалет уха, промывание, для освобождения от отделяемого и эпидермальных масс. Дополнительно можно использовать методы физиолечения: тубус-кварц или лазеротерапию.
Болезнь работает в симбиозе
Ситуацию усложняет то, что Эрвиния поражает деревья совместно с другими патогенами. Исследования подтвердили, что на больных грушах с высокой вероятностью могут появляться бактерии местной формы и Pseudomonas syringae, вызывающие пятнистость листьев, бурое слезотечение и повреждение плодов.
Бактериям свойственно составлять симбиотические пары с грибками. У груш и яблонь, страдающих от ожога, также вероятен монилиоз (плодовая гниль), который возбуждает грибок Monilia fructigena.
Гниль проявляется бурыми разрастающимися пятнами на плодах. При высокой влажности на них образуются кольца серого или светло-желтого спороносного налета. В сухую погоду плоды приобретают сине-черную окраску и мумифицируются.

На яблонях возможно появление парши, вызываемой грибком Venturia inaegualis, но груши он не поражает.
Болезнь можно узнать по пятнам, покрытым на листьях серо-зеленым налетом, а на плодах темно-оливковым слоем спор, часто с серой каймой.
Мякоть под пятном приобретает пробковую структуру, фрукты могут деформироваться, в некоторых случаях и растрескиваться.
Способствующие факторы и среда
Наиболее благоприятные условия для размножения эрвиний складываются весной, когда:
- температура воздуха повышается до +18…+20 градусов;
- часто идут дожди, так что воздух становится влажным.
Бактериальный ожог на груше развивается в несколько этапов:
- сначала страдают почки;
- затем инфекция распространяется на листья и молодые ветки;
- бактерии перемещаются по сосудам дерева и поражают ствол.
Все это приводит к появлению некротических образований, размягчению и отслаиванию коры. На этом этапе уже нет смысла спасать грушу. Лучше избавиться от нее, чтобы защитить остальные деревья.
Бактериальный рак растений
Возбудитель – бактерии рода Pseudomonas (Pseudomonas syringae, Pseudomonas tumefaciens).

Болезнь поражает плодовые деревья и кустарники (среди садовых культур подвержены практически все, но чаще яблони и груши) в комнатном цветоводстве встречается на плодовых экзотах (киви, авокадо и т.п.) и цитрусовых. Бактерии — возбудители живут в почве и долго в ней сохраняются. Поэтому распространяется болезнь с необеззараженной почвой, а также с зараженным прививочным материалом.
Бактерии поражают сосудистую систему, вызывая на корнях, стеблях, стволах образование сначала трещин, почернения, деформации тканей, затем развития опухолей, которые временами достигают огромных размеров в несколько килограмм. На плодоносящих деревцах на плодах признаки заболевания проявляются вначале небольшими мелкими округлыми пятнами, вначале светлыми, затем чернеющими. Затем на их месте вырастаю бугорки, превращающиеся в безобразные бородавки. У цитрусовых пятна и бородавки не проникают и не разрастаются внутрь плодов, но нарушает их созревание и хранение.
В природе распространению болезни способствуют низкие температуры, сильный ветер и обильные дожди. Самое печальное, что болезнь развивается медленно и обнаружить признаки поражения можно через несколько месяцев, даже через год после покупки саженца или культурного деревца (в редких случаях болезнь развивается за пару недель). Способствуют развитию болезни большие дозы азотистых удобрений.
Меры борьбы
Меры борьбы с бактериальным раком эффективны только в том случае, если поражение местное и бактерии не попали в сосудистую систему растения. Лекарственных средств в борьбе с бактериальным раком не существует. Единственная разумная рекомендация — уничтожит растение, причем так, чтобы не заражать окружающую среду (например, сжечь). Как мера профилактики — дезинфекция инструмента (секаторов, ножей) 1% раствором медного купороса (100 г на 10 л воды), замачивание в течение 5-10 минут. При пересадке растений старые горшки нужно не только мыть, но и тщательно споласкивать кипятком внутри и снаружи.
Землю можно дезинфицировать прогреванием в духовке — бактерия погибает при температуре выше 50°С. При работе с больным или подозрительным растением необходимо обрабатывать спиртом и руки, чтобы при соприкосновении со здоровым растением не заразить его. Хотя переносчиками могут быть и насекомые-вредители. При пересадке старайтесь не повредить корни, а если это произошло, то присыпайте поврежденное место толченым древесным углем, сломы или спилы древесины — садовым варом, чтобы запечатать «ворота» для инфекции.
При покупке привитых цитрусовых, саженцев плодово-ягодных деревьев и косточковых, внимательно осматривайте растения. Опасения вызывают те, что имеют трещины на коре, деформированные, как бы гофрированные листья и любые наросты, а также небольшие пятнышки на плодах.
Этапы консультации при запросе на средства для полоскания горла

Источники
- Старостина С. В. Боль в горле: эффективность топической терапии //РМЖ, 2014. Т. 22. № 9. С. 666–669.
- Мальцева Г. С. Острая боль в горле // Cons. Med, 2012. Т. 14. № 3. С. 78–81.
- Принципы этиопатогенетической терапии острых фарингитов. Методические рекомендации / Составитель: С. В. Рязанцев. — Спб.; — 32 с.
- Туровский А. Б., Кудрявцева Ю. С. Современный подход к лечению боли в горле // РМЖ, 2012. Т. 20. № 9. С. 471–474.
- Frye R., Bailey J., Blevins A. Which treatments provide the most relief for pharyngitis pain? //Clinical Inquiries, 2011 (MU). — 2011.
- Noda T. et al. Gargling for oral hygiene and the development of fever in childhood: a population study in Japan // Journal of epidemiology. 2012; 22 (1): 45–49.
- Муравьева Д. А., Самылина И. А., Яковлев Г. П. Фармакогнозия. — Медицина, 2007.
- Государственный реестр лекарственных средств http://grls.rosminzdrav.ru
Солевые полоскания
Солевой раствор можно отнести к одним из наиболее популярных средств для полоскания при боли или воспалении в горле. Его эффективность обусловлена способностью предотвращать пересыхание слизистой оболочки глотки и миндалин, и таким образом препятствовать образованию микротрещин, а также дальнейшему развитию воспалительного процесса .
Положительный эффект дает полоскание морской водой. В отличие от раствора натрия хлорида, морская вода оказывает некоторое антисептическое действие за счет содержания йода. К тому же в ее состав входят микроэлементы, способствующие укреплению местного иммунитета, такие как цинк и селен.
Гипертонические растворы оказывают осмотическое и тканевое давление на микрофлору, вследствие чего нарушается функция клеточных мембран и бактерии погибают. Не следует сбрасывать со счетов и возможность солевых растворов механически смывать возбудителей инфекции с миндалин и задней стенки глотки .
Полоскание солевыми растворами рекомендуют назначать при боли в горле не только отечественные, но и западные специалисты . Раствор натрия хлорида и морская вода помогают уменьшить выраженность легкой и умеренной боли в горле, однако при сильном болевом синдроме, согласно международным рекомендациям по лечению боли в горле, следует сочетать его с приемом анальгетиков, таких как парацетамол и ибупрофен .
Кстати, вполне можно предложить посетителю, которого тревожит сильная боль в горле, сочетать полоскание с приемом безрецептурных НПВП. Таким образом, получаем уместную и «клинически обоснованную» допродажу ЛС.
Необходимо подчеркнуть, что растворы натрия хлорида или морской соли — оптимальная рекомендация, если нужно определиться со средством для полоскания горла именно для детей, т. к. возрастных ограничений нет: главное, чтобы ребенок уже умел выполнять эту процедуру. К тому же солевые растворы для полоскания помогают не только облегчить боль в горле, но и проявляют профилактический эффект в отношении возбудителей респираторной инфекции.
По данным исследований японских ученых с участием более 19 500 детей 2–6 лет, полоскания горла раствором соли, зеленым чаем и даже водопроводной водой по крайней мере один раз в день снижали вероятность ОРВИ и лихорадки при ОРВИ .
В ассортименте аптек солевые растворы в основном представлены в спреях для орошения. Для полоскания можно предложить раствор натрия хлорида изотонический, стерильный для инфузий или остановить выбор на порошках. Как правило, они содержат еще и йод, экстракты растений и другие ингредиенты.
Злокачественный наружный отит (некротический наружный отит)
Эту форму наружного отита выделяют в отдельную, но фактически он является негативным течением обычного диффузного наружного отита. В процессе заболевания происходит распространение воспаления на структуры височной кости, может возникать поражение черепно-мозговых нервов и развитие внутричерепных осложнений. Название заболевания не связано с развитием злокачественной опухоли, просто таким образом отражается течение заболевания. К счастью, это заболевание встречается редко, болеют пациенты с тяжелыми нарушениями иммунитета, такими как СПИД, состояние после лучевой и химиотерапии, декомпенсированный сахарный диабет, пациенты, получающие иммуносупрессивную и цитостатическую терапию. Ведущим возбудителем признана синегнойная палочка, но любая инфекция полимикробна. В процессе воспаления происходит некроз кожи слухового прохода и переход воспаления на надкостницу и кость, с последующим её разрушением. Жалобы при данном заболевании на сильную боль, выделения из уха гнойно-воспалительного характера, с гнилостным запахом, быстро наступает снижение слуха. Позднее присоединяются симптомы поражения черепно-мозговых нервов: затруднение глотания, попёрхивание при приёме пищи, онемение лица, паралич лицевых мышц. При распространении процесса в среднее и внутреннее ухо может развиваться системное головокружение. При распространении воспаления в полость черепа развивается общемозговая и менингеальная симптоматика. При осмотре обращает на себя выраженное воспаление кожи НСП, кожа с очагами некроза, большое количество гнойно-некротического отделяемого, барабанная перепонка и структуры среднего уха часто неопределимы. Определяются симптомы поражения черепно-мозговых нервов-асимметрия лица, птоз нижнего века на стороне поражения, асимметрия мягкого нёба, нарушение подвижности надгортанника. В диагностике важен посев на бактериологическое исследование, компьютерная томография височных костей. Лечение проводится всегда в условиях стационара. Проводится массивная антибактериальная и дезинтоксикационная терапия. Назначаются инфузии человеческого гамма-глобулина, антисинегнойной сыворотки или гипериммунной человеческой плазмы. Также проводится хирургическое лечение — некротомия (удаление некротизированных участков кожи и кости), в последующем при выздоровлении проводится пластика дефекта собственными тканями.
Симптомы и причины возникновения болезни
Первые признаки заболевания становятся видны уже весной. Основные симптомы, свидетельствующие о нападении опасной болезни следующие:
- молодые веточки начинают усыхать, деформируются и приобретают форму крючка;
- кора дерева приобретает рыжеватый оттенок;
- плоды на высохших ветвях чернеют и мумифицируются;
- листва на деревьях также приобретает черный оттенок и осыпается;
- на поверхности растения появляются капельки мутной беловатой жидкости;
- почки останавливаются в развитии;
- распустившиеся соцветия постепенно темнеют и засыхают.
Распространение инфекции между растениями осуществляется четырьмя основными путями:
- по ветру. Из вязкого вещества экссудата образуются тонкие нити, которые разносятся ветром на другие растения. Возбудитель начинает размножатся, попадая на соцветия или в открытые раны дерева;
- с каплями дождя. Возбудитель может распространятся на соседние растения в капельках дождевой воды, благодаря сильным порывам ветра;
- через садовые инструменты. При выполнении санитарной обрезки и формировки, инфекция может оставаться на поверхности инструментов. Если при переходе на другое растение инструмент не дезинфицировать как следует, то болезнь с легкостью поразит и его;
- с помощью насекомых. Чаще всего причиной распространения являются пчелы. Опыляя деревья они переносят инфекцию с цветка на цветок. Однако и другие вредители, способные перемещаться между разными растениями, также могут разнести заболевание по саду.
Как спасти сад от бактериального ожога?
Для защиты садов от бактериального ожога плодовых культур государство, как правило, применяет карантинные меры в виде временного запрета на ввоз восприимчивых к болезни плодовых культур и их саженцев из тех регионов, где она обнаружена. Но в полной мере это ситуацию не спасает, поскольку американская эрвиния, напомним, переносится ветром, насекомыми, а также птицами. Это означает, что по весне каждый садовод должен быть начеку и беречь свои розоцветные культуры как зеницу ока.
Самое главное – это при установлении температуры воздуха на отметке 20°C регулярно осматривать свои кустарники и деревья на предмет появления подозрительных молочно-белых капель, которые на воздухе постепенно становятся бурыми. Кроме этого, на заболевшем растении обязательно отыщутся усохшие молодые побеги, изогнутые в виде крючка, а в более запущенных случаях – усохшие цветки и мумифицированные плоды на побегах и цветоножках.
Если болезнь обнаружена, пора сразу же переходить к решительным действиям.
Трещину, из которой выделяется белый вязкий экссудат, зачистите от грубой коры, затем растворите таблетку Офлоксацина в 1 л воды, смочите в этом растворе кусок марли и наложите его на поврежденное место дерева, сверху обмотайте пленкой и закрепите ее.
В самом начале сокодвижения растение под корень поливают препаратом Превикур Энерджи, который блокирует распространение заразы внутри дерева.
В целях профилактики заболеваний деревьев можно не позже, чем за 10 дней до цветения, опрыскать все дерево раствором воды с Офлоксацином (2 таблетки на 10 л).
На стадии набухания бутонов нужно обработать деревья антибиотиками. Опытные садоводы советуют использовать для этих целей Ампициллин в количестве 1 г на 10 л, а дополнительно добавить в раствор стакан сахара и 1 ст.л. меда. Это делается для того, чтобы пчелы и мухи, которые прилетят в ваш сад, питались исключительно этим нектаром, избегая белых капель американской эрвинии, и не переносили вредную бактерию.
Обработку антибиотиком рекомендуется производить дважды до цветения и единожды – в самом его начале.
В дополнение к антибиотикам после окончания срока их действия специалисты советуют дополнительно обработать сад аэрированным компостным чаем.
Цветущий и отцветающий сад обрабатывают смесью Скора с Фитолавином, а при отрастании побегов применяют Цинеб, Ридомил Голд или Акробат.
В середине лета во влажную погоду сад опрыскивают Фитолавином либо смесью Ампициллина и Офлоксацина дважды с перерывом в одну неделю. А для осенней обработки плодовых культур лучше всего подойдут препараты, содержащие тиобациллы.
Бактериальный ожог плодовых культур – опасная болезнь, уничтожившая множество растений семейства Розоцветные в нескольких странах мира. К сожалению, борьба с ней возобновляется из года в год. Но уберечь от нее свой сад, как видим, вполне реально. Перефразируя известное правило, получим вывод: «Помоги своему саду сам!» Кстати, а вам эта болезнь где-нибудь встречалась?
Что делать, если на деревьях появились черные пятна
Обнаружили черные пятна на ветках, листьях или бутонах плодовых деревьев? Срочно нужно выяснить, в чем дело и как лечить сад.
Груша и особенности развития болезни

Американка быстро размножается при температуре в 20 градусов и стремительно увеличивает свою численность при температуре выше 25 градусов.
Это заболевание прогрессирует, в основном, в дождливый период (начало июня). Болезнь проходит несколько стадий.
- Увядание монилиальное. Поражаются соцветия груш как по одиночке, так и группами. Цветочки на этом дереве становятся вялыми и постепенно засыхают. Со временем инфекция поражает всё новые и новые участки, направляясь книзу ствола. Цветоножка сначала становится зелёной, а потом янтарной. Затем очередь доходит до почек дерева, которые становятся тёмного цвета. Потом коричневеют листья, но остаются висеть на дереве. Как только инфекция просачивается в корни дерева, то стазу же попадает вовнутрь ствола. Ствол покрывают бурые пятна, кора высыхает и покрывается трещинами. На поражённых участках выступают молочно-белые пятна. При таком развитии заболевания дерево спасти уже практически невозможно.
- Высыхание листвы.
- Высыхание всех веток.
- Поражение завязи.
Профилактические действия

Поражение кадмия можно увидеть, если срезать ножом кору.
Стоит помнить, что предупредить заболевание намного легче, чем потом вылечить дерево. Стоит помнить о проведении таких мероприятий:
За каждым новым грушевым деревом необходимо постоянно следить. Место высадки нужно регулярно пропалывать, чтобы не разводилась сорная трава, которая может стать непосредственной причиной инфекционного заболевания.
При посадке саженцев инвентарь нужно использовать только чистый.
При выборе саженцев старайтесь выбрать такой сорт, который устойчив к такому заболеванию, как бактериальный ожог.
Если недалеко от вашего сада есть заброшенные фруктовые деревья, необходимо их выкорчевать
Они также может стать источником заболевания.
Стараться регулярно обрабатывать сад инсектицидными средствами для того, чтобы минимизировать количество паразитирующих насекомых (ос, мух), через которые и происходит перенос вредных микроорганизмов.
С регулярностью и особой тщательностью необходимо наблюдать за садом, особое внимание уделять листикам и соцветиям. Как только вы выявили первые признаки заболевания, немедленно приступайте к соответствующим комплексным мерам, которые вначале локализуют инфекцию, а потом и устранят её.







